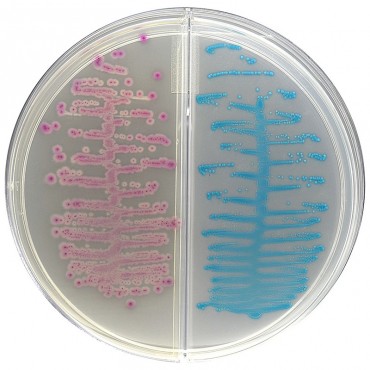

HardyCHROM™ Urine Biplate
CAD$81.89
Chromogenic Media
FILTER BY
Chromogenic media contain a combination of selective ingredients and chromogenic substrates that when incubated with the target bacteria, produce a distinct colour. This allows for easier, faster and more accurate bacterial identification, reducing the need for subsequent biochemical tests.
There are 2 products.
Sort by: